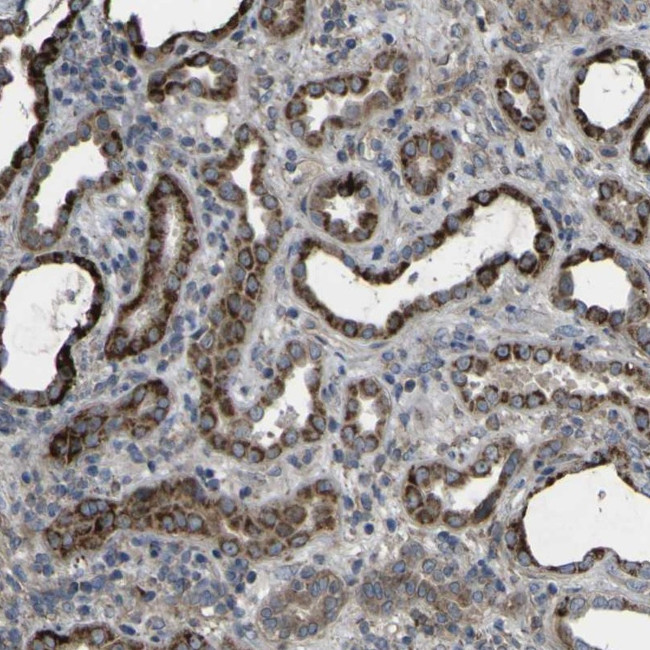
GPLD1 Antibody in Immunohistochemistry (Paraffin) (IHC (P))

Search
Invitrogen
GPLD1 Polyclonal Antibody
{{$productOrderCtrl.translations['antibody.pdp.commerceCard.promotion.promotions']}}
{{$productOrderCtrl.translations['antibody.pdp.commerceCard.promotion.viewpromo']}}
{{$productOrderCtrl.translations['antibody.pdp.commerceCard.promotion.promocode']}}: {{promo.promoCode}} {{promo.promoTitle}} {{promo.promoDescription}}. {{$productOrderCtrl.translations['antibody.pdp.commerceCard.promotion.learnmore']}}
产品信息
PA5-52941
种属反应
宿主/亚型
分类
类型
抗原
偶联物
形式
浓度
规格
纯化类型
保存液
内含物
保存条件
运输条件
RRID
产品详细信息
Immunogen sequence: FWSTNIYHLT SFMLENGTSD CNLPENPLFI ACGGQQNHTQ GSKMQKNDFH RNLTTSLTES VDRNINYTER GVFFSVNSWT PDSMSFIYKA LERNIRTMFI GGSQLSQKHV SS
Highest antigen sequence identity to the following orthologs: Mouse - 65%, Rat - 68%.
靶标信息
GPLD1 is expressed in numerous tissues and cells and specifically cleaves GPI-anchored proteins. Liver has the highest level of GPI-PLD expression and is the primary organ contributing to GPLD1 in the serum. GPLD1 is abundant in serum in which it associates with polipoproteins AI and AIV. Increased serum GPLD1 is associated with insulin resistance and elevated serum triglycerides. Many surface proteins are attached to eukaryotic cell membranes via glycosylphosphatidylinositol (GPI) anchors that are covalently bound to the C-terminus of the protein and cleavage of the GPI moiety by GPLD1, only enzyme known that cleavage GPI anchor, may represent a means of regulating attachment of these proteins to the cell surface, or alternatively, their release into the extracellular environment.
仅用于科研。不用于诊断过程。未经明确授权不得转售。
篇参考文献 (0)
生物信息学
蛋白别名: Glycoprotein phospholipase D; Glycosyl-phosphatidylinositol-specific phospholipase D; GPI-PLD; GPI-specific phospholipase D; MGC22590; Phosphatidylinositol-glycan-specific phospholipase D; PI-G PLD
基因别名: GPIPLD; GPIPLDM; GPLD1; PIGPLD; PIGPLD1; PLD
UniProt ID: (Human) P80108
Entrez Gene ID: (Human) 2822